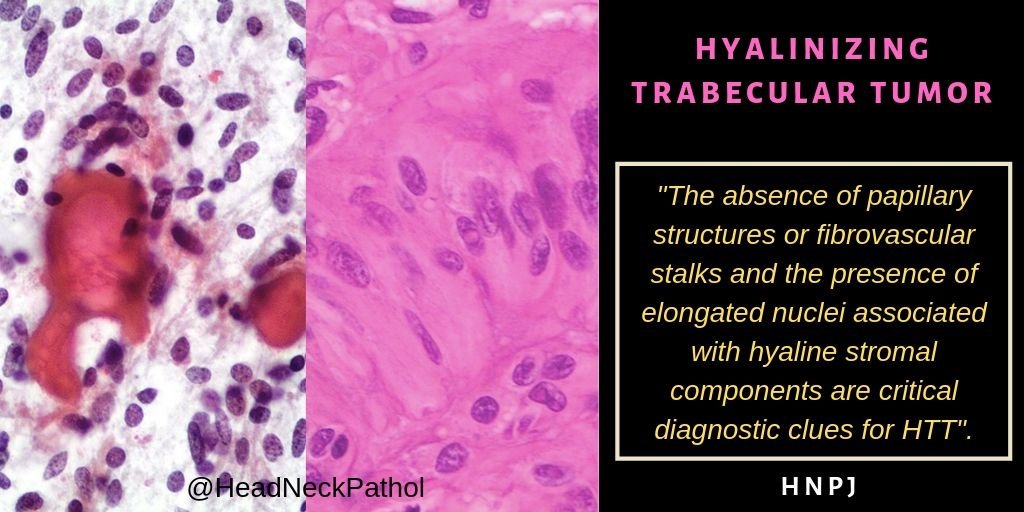
Gerônimo Jr. tweet media

Sabitlenmiş Tweet
Nejib Ben Yahia, MD
3.7K posts


Nejib Ben Yahia, MD
@NejibY
Pathologist, former Assistant Professor of Pathology in FB Univ Hospital, Monastir and Resident in Paris (Saint-Antoine & Antoine Béclère). Liberal practice
Djerba, Tunisia Katılım Eylül 2014
1.3K Takip Edilen3.6K Takipçiler
Nejib Ben Yahia, MD retweetledi
Nejib Ben Yahia, MD retweetledi

Thanks to @ArkansasOnline & @wernertplays for featuring me in the high profile section of today’s paper! I’m honored. 🙏🏻 arkansasonline.com/news/2020/feb/… #pathology #pathologists #medtwitter

English
Nejib Ben Yahia, MD retweetledi

Tune in @8AM tomorrow with Dr @RaulSGonzalezMD #AppendicealPath @pembeoltulu @JHUPath @LizMontgomeryMD @Voltaggiol @ALBoothMD @CArnold_GI @Pathologists @AIPNAPathology @pathrescue @emma_furth @pezhouh @feldmanm30 @RhondaYantiss @TheUSCAP @GeronimoJrLapac @aakasharmand
pathCast@pathologyCast
Tomorrow @ 8AM EST: we welcome back Dr @RaulSGonzalezMD for an hour on #AppendicealPath #GIPath
English
Nejib Ben Yahia, MD retweetledi

I am being interviewed by #PhoenixMagazine tomorrow about #Pathart. They asked me if I had a studio (ummm, no). I set this up today in my office for the photos. I think it’s going to be in the April Top Docs edition. So nervous and excited! #pathology

English
Nejib Ben Yahia, MD retweetledi
Nejib Ben Yahia, MD retweetledi

Soft Tissue Special Issue: Myoepithelial Neoplasms of Soft Tissue: An Updated Review with Emphasis on Diagnostic Considerations in the Head and Neck by Dr. Vickie Y. Jo
rdcu.be/b0Zuu
#HeadNeckPathol #HNPJ #HeadandNeckPath #Pathology #ENTPath #PathologyTweet


English
Nejib Ben Yahia, MD retweetledi

Soft Tissue Special Issue: Cutaneous Pleomorphic Spindle Cell Tumors by Dr. Thomas Brenn.
rdcu.be/b0WcY
#HeadNeckPathol #HNPJ #HeadandNeckPath #Pathology #ENTPath #PathologyTweet


English
Nejib Ben Yahia, MD retweetledi

Soft Tissue Special Issue: Imaging of Bone and Soft Tissue Sarcomas in the Head and Neck by Ngoc-Anh Tran, Jeffrey P. Guenette & Jyothi Jagannathan:
link.springer.com/article/10.100…
#HeadNeckPathol #HNPJ #HeadandNeckPath #Pathology #ENTPath #PathologyTweet

English

🧑4y old male patient with an encapsulated, non-invasive and mostly homogenous mass in right kidney, compressing the sinus fat and protruding in calyces and ureter.
#grosspath #grossognosis #pathology




English
Nejib Ben Yahia, MD retweetledi

Epstein–Barr Virus-Positive Large Cell Neuroendocrine Carcinoma of the Nasopharynx: Report of One Case and Review of the Literature, @HeadNeckPathol link.springer.com/article/10.100…
@HeadandNeckPath @ENTpathology @GeronimoJrLapac @NejibY

English
Nejib Ben Yahia, MD retweetledi

Colon Cancer Metastasis Within a NIFTP: A Case Report and Review of the Literature
rdcu.be/bU5po
#HeadNeckPathol #HNPJ #HeadandNeckPath #Pathology #ENTPath #PathologyTweet


English
Nejib Ben Yahia, MD retweetledi

The day has come! Here are the winners of IIIrd International PathArt Photomicrography Contest! Congrats to all the winners! 👏🏻
Please click on the link to see the winners and the photos of all the contestants: turkjpath.org/contest_2019.p…
@pembeoltulu @sultan_clskn_dr @OlgerHatice

English
Nejib Ben Yahia, MD retweetledi

Such a nice surprise in a skin bx #PathArt #pathology
@smlungpathguy @JMGardnerMD @GeronimoJrLapac @MPathyart @IHeartHisto @AmyHDeekenMD @rositadeolivop1 @luishcruzc @sam_albadri @PathologySayah @DrRolaAli @preethijaison @Halima81819652 @raghupillappa @NejibY @HermelinDaniela

English
Nejib Ben Yahia, MD retweetledi

Nejib Ben Yahia, MD retweetledi

Macro/Micro correlation of a Gastric leiomyoma, a rare benign mesenchymal tumor
(Desmin+, SMA+, CD34-, CD117-, DOG1-) Provided by my #GIpath colleague Isabel Amengual #grosspath


Palma, Spain 🇪🇸 English
Nejib Ben Yahia, MD retweetledi

⚠️Tips and Pitfall alerts in the evaluation of Hyalinizing Trabecular Tumor. It is worth checking ! ⚠️
☑️link.springer.com/article/10.100…
#HNPJ #Entpath #pathology @HeadandNeckPath @HeadNeckPathol @pembeoltulu @NejibY

English
Nejib Ben Yahia, MD retweetledi

Thymoma review by Robert P Hasserjian MD. @kriyer68 @pembeoltulu @sam_albadri @smlungpathguy @suraksharaob @NejibY @raghupillappa @Missle


English
Nejib Ben Yahia, MD retweetledi

⚠️PITFALL ALERT - CEREBELLAR HEMANGIOBLASTOMA⚠️
#Neuropath #pathology
Ps: Similar gliosis can be seen in ependymomas, gangliogliomas, low grade gliomas ...🧐🔬

Lietuvių
Nejib Ben Yahia, MD retweetledi

Nothing rare or unusual here.........just a Seminoma with classic gross appearance.......#gupath @Pathologists

English





